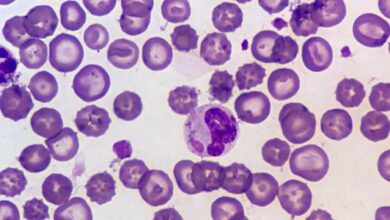

محتويات

يُعزى اضطراب الهرمونات بشكلٍ عامّ إلى العديد من العوامل والأسباب، نذكر منها ما يأتي:[١][٢]
- اضطراب في نظام التغذية الراجعة الخاصّ بجهاز الغُدد الصمّاء (بالإنجليزية: Endocrine system).
- فشل غُدة مُعينة في تحفيز غُدة أخرى لإفراز الهرمونات.
- تكون الأورام الصماوية المتعددة (بالإنجليزية: Multiple endocrine neoplasia) وقصور الغدة الدرقية الخَلقي (بالإنجليزية: Congenital hypothyroidism).
- التعرّض للعدوى.
- إصابة الغدد الصمّاء.
- أورام وعُقيدات الغدد الصمّاء.
- الضغوط النّفسية المُزمنة والشديدة.
- النّوع الأول والثاني من مرض السكّري.
- فرط سكر الدم (بالإنجليزية: Hyperglycemia) ونقص السكر في الدم (بالإنجليزية: Hypoglycemia).
- قصور الدرقية (بالإنجليزية: Hypothyroidism)، وفرط نشاط الغدة الدرقية (بالإنجليزية: Hyperthyroidism).
- زيادة أو نقصان إنتاج الهرمون جار الدرقي (بالإنجليزية: Parathyroid hormone).
- سوء التغذية.
- السّمنة.
- الاستخدام الخاطئ للمُنشِّطات البِنائيّة (بالإنجليزية: Anabolic Steroids).
- أورام الغدة النّخامية (بالإنجليزية: Pituitary gland).
- متلازمة كوشينغ (بالإنجليزية: Cushing’s Syndrome).
- مرض أديسون (بالإنجليزية: Addison’s Disease).
- فرط تنسج الكظرية الخَلقي (بالإنجليزية: Congenital adrenal hyperplasia).
- الحساسية الشديدة.
- السرطانات التي تحدث في الغدد الصماء.
- الخضوع للعلاج الكيميائي والإشعاعي.
- نقص اليود المُتمثل بتضخم الغدة الدرقية (بالإنجليزية: Goiter).
- التهاب البنكرياس (بالإنجليزية: Pancreatitis) الوراثي.
- متلازمة تيرنر (بالإنجليزية: Turner syndrome).
- متلازمة برادر- ويلي (بالإنجليزية: Prader-Willi syndrome).
- فقدان الشهية العصابي (بالإنجليزية: Anorexia).
- التعرّض للسموم، والملوثات، والمواد الكيميائية ذات التأثير في الغدد الصماء.
إلى جانب الأسباب سابقة الذكر قد تؤدي عوامل أخرى إلى اضطراب الهرمونات في جسم المرأة، وفيما يأتي بيان لأبرزها:[٣]
- بلوغ سن اليأس (بالإنجليزية: Menopause).
- انقطاع الطمث المُبكّر.
- الحمل.
- الرضاعة الطبيعية.
- متلازمة تكيّس المبايض (بالإنجليزية: Polycystic ovarian syndrome).
- استخدام حبوب منع الحمل.
- قصور المبيض الأولي (بالإنجليزية: Primary ovarian insufficiency).
يُعزى حدوث اضطرابات الهرمونات لدى الرجال إلى العوامل التي ذُكرت سابقاً في بند اضطراب الهرمونات بشكلٍ عامّ، إضافةً إلى عوامل أخرى مُتعلّقة بالرجال دون النّساء، وفيما يأتي بيان لأبرزها:[٢]
- سنّ البلوغ.
- التقدّم في العمر.
- سرطان البروستاتا (بالإنجليزية: Prostate cancer).
- قصور الغدد التناسلية (بالإنجليزية: Hypogonadism).
- ↑ “Endocrine Disorders”, www.webmd.com, Retrieved 2-2-2019. Edited.
- ^ أ ب “What to know about hormonal imbalances”, www.medicalnewstoday.com, Retrieved 2-2-2019. Edited.
- ↑ “Everything You Should Know About Hormonal Imbalance”, www.healthline.com, Retrieved 2-2-2019. Edited.